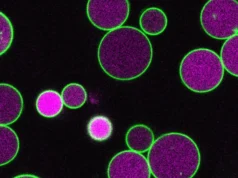
Cientistas acabam de descobrir o que impede as células vegetais de crescerem descontroladamente

Os betabloqueadores – geralmente medicamentos preservados para várias condições cardíacas, incluindo ataque cardíaco – não fornecem nenhuma instalação clínica para pacientes com um infarto do miocárdio complexo com a função cardíaca. Os betabloqueadores são padronizados para esses pacientes por 40 anos.
O investigador sênior Valentin Foster, MD, PhD, Mount Sinai Fuster Heart Hospital Presidente e Diretor Sênior (CNIC) do Centro Nasional de Investigasiones da Espanha (CNIC) é uma “reinicialização”. Os resultados da pesquisa, que podem reverter o exemplo de um tratamento padrão, foram publicados durante uma sessão de “linha quente” na Sociedade Europeia do Congresso de Cardiologia no sábado, 30 de agosto New England Journal of Medicine.
Além disso, uma opção de reinicialização publicada em 30 de agosto Jornal do Coração Europeu, Isso mostra que as mulheres que são tratadas com betabloqueadores estavam mais em risco de doenças cardíacas, ataque cardíaco ou admissão hospitalar do que mulheres que não tomaram medicamentos. Os homens não aumentaram esse risco.
“Todas as diretrizes clínicas internacionais deste estudo serão exibidas. Ele se junta a outros ensaios anteriores de referência liderados pelo CNIC e pelo Monte Sinai – como protegidos com Polypil e Dapatabi, relacionados à inibição do SLT2 TAVI – que já converteu alguns procedimentos globais em doenças cardiovasculares”.
O teste protegido mostrou um Polypil, uma única pílula que combina três medicamentos – ele contém aspirina, rampril e atorvastatina – eventos cardiovasculares em pacientes tratados após um ataque cardíaco reduzir os eventos cardiovasculares em 33 %. Ensaios de Dapatavi tanto dapaglifologia quanto de medicamentos relacionados ampaglifologina – ambos os medicamentos usados para o tratamento do diabetes mostraram a válvula ortical transcatadora para melhorar o diagnóstico de pacientes com estenose oórtica tratados.
“A reinicialização mudará a prática clínica global”, o diretor científico da CNIC, o investigador principal Borza Ibiez, que apresentou os resultados. “Atualmente, mais de 5 % do complexo infarto do miocárdio foram libertados em bloqueadores beta. A pesquisa de reinicialização representa um dos progressos mais significativos no tratamento de ataques cardíacos por décadas”.
Embora geralmente considerados seguros, os betabloqueadores podem causar efeitos colaterais como fadiga, bradicardia (baixa frequência cardíaca) e disfunção sexual. Por mais de 40 anos, os betabloqueadores foram determinados como um tratamento padrão após um ataque cardíaco, mas sua vantagem no tratamento moderno foi desnecessário. Reinicie o ensaio, o maior ensaio clínico nesse sentido. A pesquisa internacional foi integrada pelo CNIC em colaboração com o Mario Negary Institute for Pesquisa Farmacológica para Pesquisa Farmacológica de Milão.
Os pesquisadores admitiram 8.505 pacientes em 109 hospitais na Espanha e na Itália. Os participantes foram empregados aleatoriamente para receber ou não aceitar os betabloqueadores após a alta hospitalar. Todos os pacientes receberam o valor atual do atendimento e seguiram por cerca de quatro anos. Os resultados não mostram diferença significativa entre os dois grupos na taxa de admissão hospitalar para a taxa de mortalidade, um ataque cardíaco recorrente ou uma insuficiência cardíaca.
Uma análise de subgrupo de reinicialização mostrou que as mulheres tratadas com betabloqueadores sentiram mais eventos adversos. Os resultados mostraram que a taxa de mortalidade foi 2,7 % maior de risco de taxas de mortalidade em comparação aos betabloqueadores durante 3,7 anos de pesquisas femininas de acompanhamento tratadas com betabloqueadores. O risco elevado quando tratado com betabloqueadores foi limitado à função cardíaca completamente normal após um ataque cardíaco (fração de 50 % ou ejeções do ventrículo esquerdo superior). A deterioração da luz na função cardíaca foi que eles não tinham risco adicional de resultados adversos durante o tratamento dos betabloqueadores.
“Após um ataque cardíaco, os pacientes geralmente são determinados por vários medicamentos, o que pode dificultar a obediência”, explicou o Dr. Ebiez. “Os betabloqueadores foram inicialmente associados ao tratamento padrão porque reduziram significativamente a taxa de mortalidade naquele momento. Seus benefícios foram associados à demanda por oxigênio cardíaco e à resistência da Arthia. Mas hoje, as artérias coronárias expiradas diminuíram de maneira rápida e regular, pois diminui como resultado.
Foi a inspiração por trás da reinicialização.
O Dr. Ibnz acrescentou: “Este teste foi criado para excluir um atendimento de ataque cardíaco sem evidências científicas e interesses comerciais sólidos.
A reinicialização foi operada sem os fundos da indústria farmacêutica.